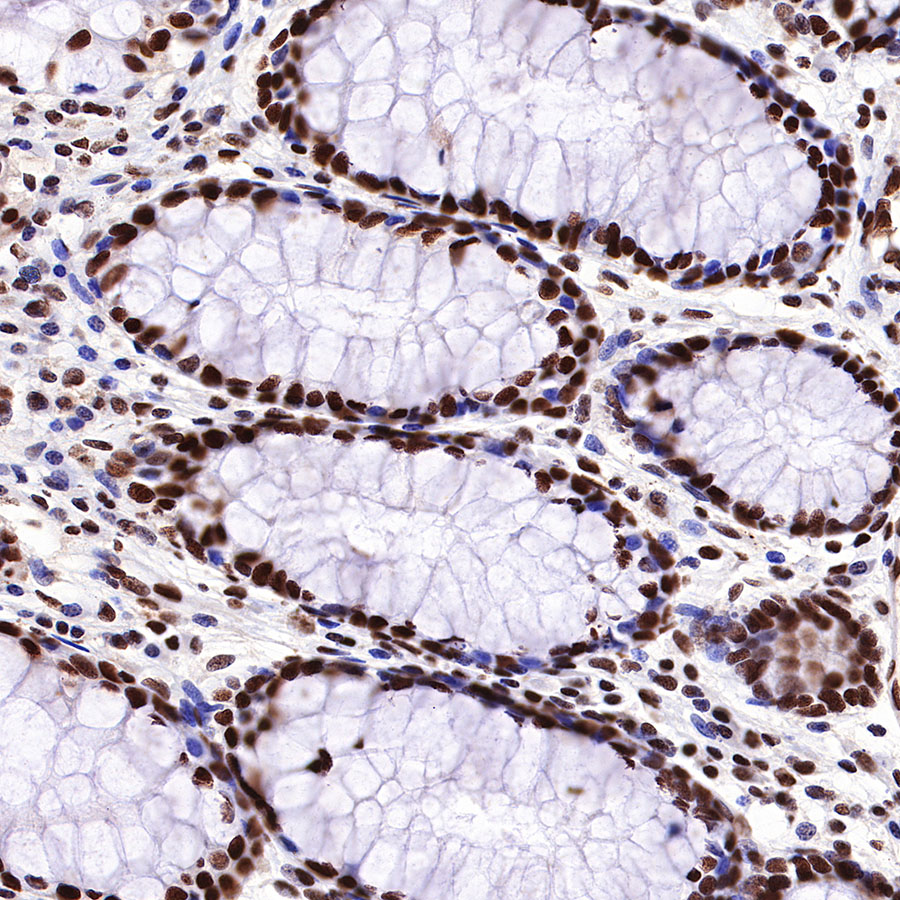
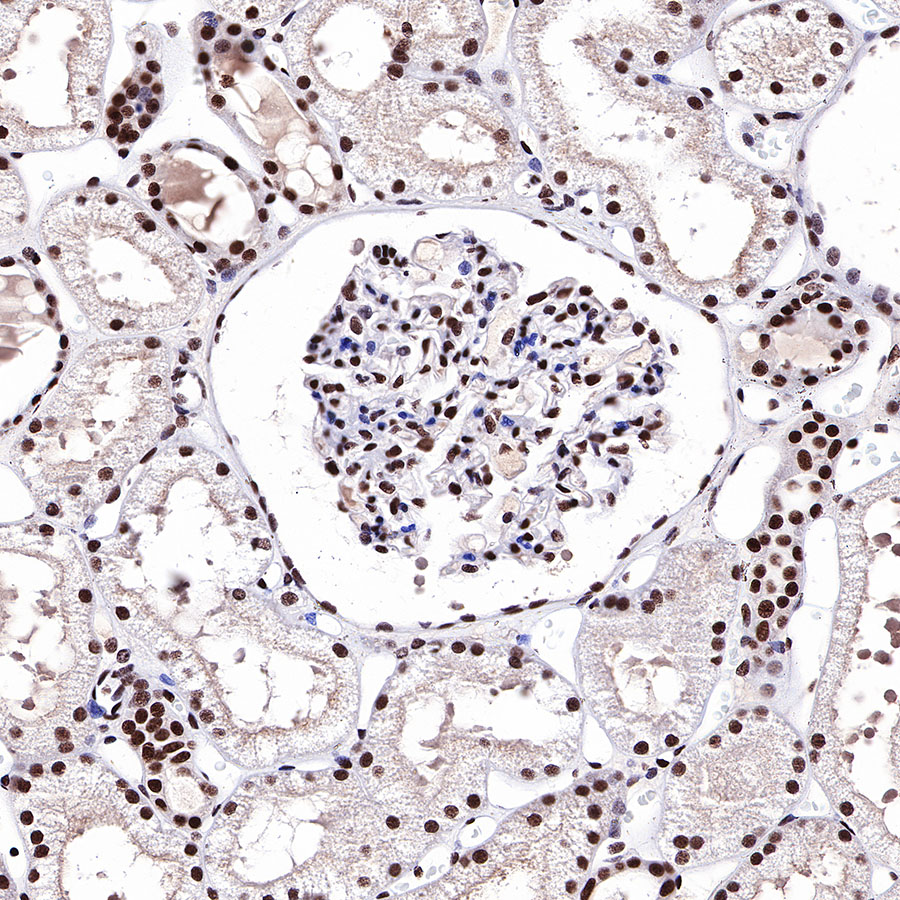

Product Details
Product Details
Product Specification
Host | Rabbit |
Antigen | HDAC1 |
Synonyms | Histone deacetylase 1, HD1, Protein deacetylase HDAC1 |
Immunogen | Synthetic Peptide |
Location | Nucleus |
Accession | Q13547 |
Clone Number | SDT-310-72 |
Antibody Type | Recombinant mAb |
Application | WB, IHC-P, ICC, ICFCM, IP |
Reactivity | Hu, Ms, Rt |
Predicted Reactivity | Bv |
Purification | Protein A |
Concentration | 0.05 mg/ml |
Physical Appearance | Liquid |
Storage Buffer | PBS, 40% Glycerol, 0.05% BSA, 0.03% Proclin 300 |
Stability & Storage | 12 months from date of receipt / reconstitution, -20 °C as supplied. |
Dilution
application | dilution | species |
WB | 1:1000-1:5000 | |
IHC-P | 1:200 | |
ICC | 1:50 | |
ICFCM | 1:50 | |
IP | 1:25 |
Background
HDAC family has four subclasses including I, II, III and IV. Histone deacetylase 1 (HDAC1) is a unique member of the classes I HDACs that has been shown to be involved in gene transcription, transcriptional regulation, cell cycle progression and developmental events by controlling both enzyme activity and epigenetics of key proteins [PMID: 16289629]. HDAC1 is the most abundant member of the class I HDACs in pulmonary endothelial cells [PMID: 34264338], regulating the enzymatic activity and epigenetics of key proteins to adapt to external stimuli. It can efficiently decrotonylate this relatively less abundant histone modification [PMID: 29317660].
Picture
Picture
Western Blot



FC

Flow cytometric analysis of 4% PFA fixed 90% methanol permeabilized HeLa (Human cervix adenocarcinoma epithelial cell) cells labelling HDAC1 antibody at 1/50 dilution (0.1 μg)/ (Red) compared with a Rabbit monoclonal IgG (Black) isotype control and an unlabelled control (cells without incubation with primary antibody and secondary antibody) (Blue). Goat Anti - Rabbit IgG Alexa Fluor® 488 was used as the secondary antibody.
IP

HDAC1 Rabbit mAb at 1/25 dilution (0.2 µg) immunoprecipitating HDAC1 in 0.2 mg HeLa whole cell lysate.
Western blot was performed on the immunoprecipitate using HDAC1 Rabbit mAb at 1/1000 dilution.
Secondary antibody (HRP) for IP was used at 1/400 dilution.
Lane 1: HeLa whole cell lysate 5 µg (Input)
Lane 2: HDAC1 Rabbit mAb IP in HeLa whole cell lysate
Lane 3: Rabbit monoclonal IgG IP in HeLa whole cell lysate
Predicted MW: 55 kDa
Observed MW: 62 kDa
Immunohistochemistry

Immunocytochemistry

ICC shows positive staining in HeLa cells. Anti-HDAC1 antibody was used at 1/50 dilution (Green) and incubated overnight at 4°C. Goat polyclonal Antibody to Rabbit IgG - H&L (Alexa Fluor® 488) was used as secondary antibody at 1/1000 dilution. The cells were fixed with 100% ice-cold methanol and permeabilized with 0.1% PBS-Triton X-100. Nuclei were counterstained with DAPI (Blue). Counterstain with tubulin (red).










